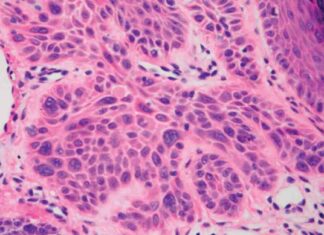
Starving Cancer Cells: Scientists’ Approach to Treating Cancer news-22092024-045828

Tag: Tumor microenvironment manipulation
Starving Cancer Cells: Scientists’ Approach to Treating Cancer
Scientists are constantly searching for new and innovative ways to treat cancer, and one approach that has garnered significant attention is starving cancer cells. Like all living things, cancer cells require nutrients to survive...